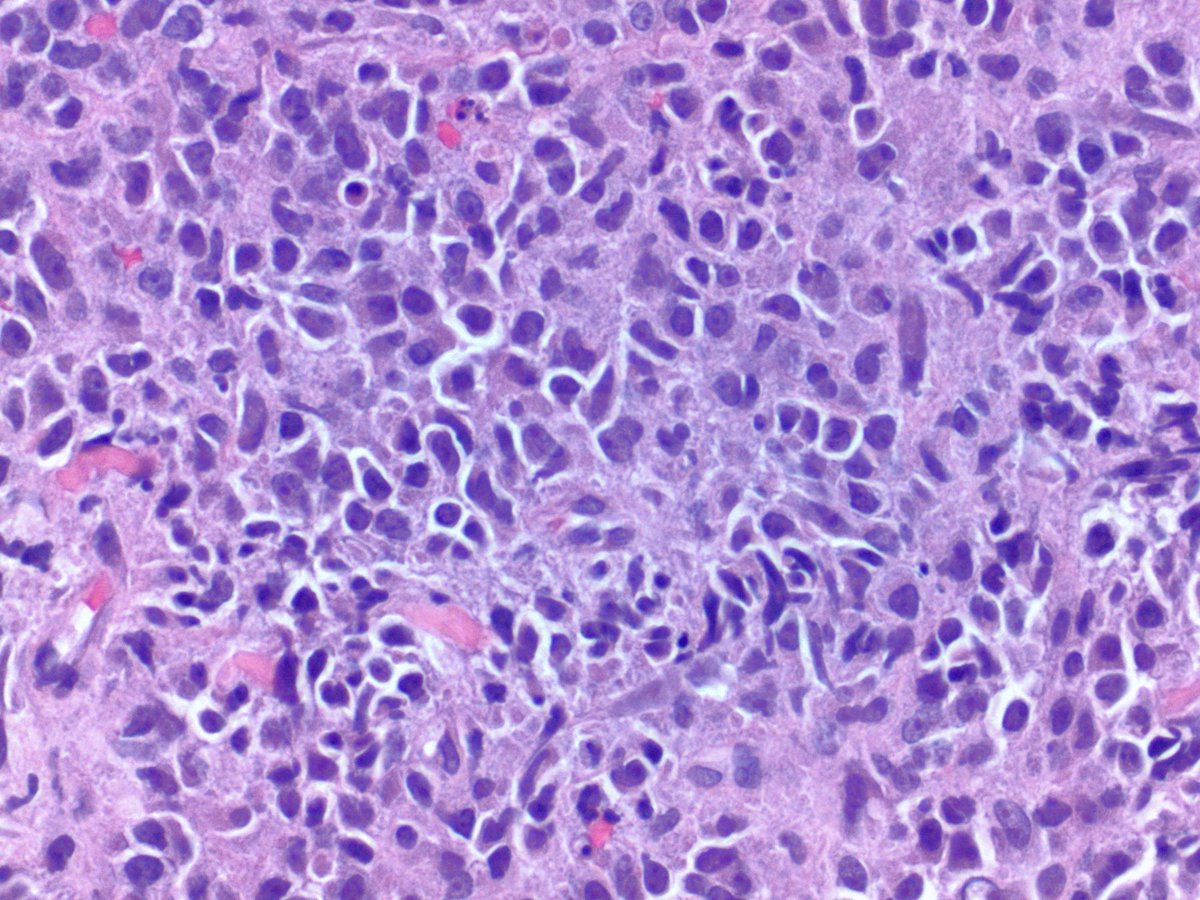
RUSH Pathology tweet media

@RushHemOnc @pvenugop @pvenugop such a wonderful honor for a wonderful person. I am so lucky to be your mentee for over 2 decades and counting.
English
Melissa
110 posts

@mlarsonmd
Director, Leukemia Program, Rush University Cancer Center, Rush University Medical Center and mom of 4 awesome kids. Tweets are my own opinion.

Our work on structural racism & AML outcomes is out in @BloodJournal! This was a Chicago-wide collab led by Dr. Abraham & @Irumkhan_hem. The big takeaway - structural racism accounts for almost all of the survival disparity in Black & Hispanic pts #leusm ashpublications.org/blood/article/…













